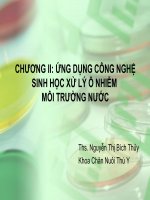
ứng dụng công nghệ sinh học xử lý ô nhiễm môi trường nước

Ứng dụng công nghệ nén ép xử lý nước rỷ
Bạn đang xem bản rút gọn của tài liệu. Xem và tải ngay bản đầy đủ của tài liệu tại đây (905.63 KB, 41 trang )
CÔNG TY CỔ PHẦN ĐẦU TƯ PHÁT TRIỂN CÔNG NGHỆ
VÀ TƯ VẤN XÂY DỰNG
Aptco VIETNAM
ƯNG DỤNG CÔNG NGHỆ
SINH HỌC NÉN ÉP
XỬ LÝ NƯỚC RỈ
TẠI BÃI CHÔN LấP CHấT THảI RắN KIÊU KỴ - GIA LÂM -
HÀ NỘI
Hà nội, Tháng 5 năm 2008
Xử lý nước rỉ rác tại bãi chôn lấp chất thải rắn Kiêu Kỵ - Gia lâm
MỤC LỤC
1. Tên dự án 2
2. Giới thiệu khái quát bãi chôn lấp chất thải rắn Kiêu Kỵ 2
3. Hiện trạng xử lý nước rỉ tại bãi chôn lấp chất thải rắn Kiêu Kỵ 3
4. Phương án xử lý nước rỉ rác bằng công nghệ sinh học nén ép
của công ty phát triển và đầu tư công nghệ APT 4
4.1. Nguyên lý cơ bản 4
4.2. Cơ sở khoa học của công nghệ nén ép sinh học 5
4.2.1.Xử lý yếm khí nén ép bằng trọng lực 6
4.2.2. Xử lý hiếu khí cưỡng bức 8
4.2.3. Ruộng chảy tràn 8
4.3. Phương án cụ thể cho trường hợp bãi chôn lấp chất thải rắn Kiêu Kỵ 11
5. Khái toán của phương án 13
6. Phân tích kinh tế 15
6.1. Giá xử lý nước rỉ rác chưa tính đến khấu hao 15
6.2. Giá xử lý nước rỉ rác có tính đến khấu hao 16
7. Đánh giá hiệu quả tổng thể 16
1. TÊN DỰ ÁN
Ứng dụng công nghệ sinh học nén ép xử lý nước rỉ tại bãi chôn lấp
chất thải rắn Kiêu Kỵ - Gia Lâm - Hà Nội
2. GIỚI THIỆU KHÁI QUÁT BÃI CHÔN LấP CHấT THảI RắN KIÊU KỴ
Công ty Cổ phần Đầu tư Phát triển Công nghệ APTCO
2
Xử lý nước rỉ rác tại bãi chôn lấp chất thải rắn Kiêu Kỵ - Gia lâm
Bãi chôn lấp chất thải rắn Kiêu Kỵ có diện tích 14 ha nằm tại xã Kiêu Kỵ,
huyện Gia Lâm được sử dụng phục vụ cho việc chôn lấp rác thải hàng ngày của 2
thị trấn: Gia Lâm, Yên Viên, và các xã của huyện Gia lâm. Bãi chôn lấp chất thải
rắn Kiêu kỵ Gia lâm là khu chôn lấp rác lớn thứ hai, sau khu liên hợp xử lý chất
thải Nam Sơn của thành phố Hà Nội. Hiện nay, lượng rác thải tập kết vào bãi
mỗi ngày vào khoảng 70 – 80 m
3
với lưu lượng nước rỉ rác trung bình là 150 m
3
.
Tuy nhiên, lượng nước rỉ rác được sinh ra mỗi ngày phụ thuộc vào nhiều yếu tố
khác nhau. Đặc biệt vào những ngày mưa bão, lượng nước rác sinh ra từ rác tăng
cao so với những ngày nắng ráo do một lượng lớn nước mưa thấm vào bãi chôn
lấp . Nhìn chung, lưu lượng nước rác dao động trong khoảng 50 - 300 m
3
/ngày.
3. Thành phần và tính chất nước rác :
Quá trình phân huỷ chất thải rắn trải qua 3 giai đoạn chính:
- Giai đoạn 1 - Phân huỷ hiếu khí: Giai đoạn này xảy ra nhanh, khoảng
thời gian đặc trưng ít hơn 1 tháng. Khi oxy có sẵn trong rác được sử dụng
hết (trừ những vùng gần bề mặt) thì pha phân huỷ hiếu khí sẽ dừng lại.
Giai đoạn này cũng có thể kéo dài một vài ngày hoặc một tuần. Với
khoảng thời gian lâu, các bãi chôn lấp chất thải rắn sẽ tạo ra một lượng đáng
kể CO
2
và H
2
(lên đến 20% thể tích), đặc biệt là những nơi chôn lấp khô
ráo. Sau một thời gian oxy cạn dần và điều kiện kỵ khí bắt đầu phát triển,
nitrat và sunphat đóng vai trò chất nhận electron trong các phản ứng
chuyển hoá sinh học, thường bị khử đến khí N2 và H2S.
- Giai đoạn 2 – Giai đoạn phân hủy kị khí: Trong giai đoạn này
các chất hữu cơ bị phân hủy (thủy phân và lên men) để tạo ra các hợp
chất đơn giản, hoà tan như là axit béo bay hơi (làm tăng giá trị BOD
5
) và
amonia nhờ các vi sinh vật kỵ khí và tùy tiện. Trong giai đoạn này pH của
nước rác bắt đầu giảm do sự hiện diện của các axit hữu cơ và ảnh hưởng
của sự gia tăng nồng độ CO
2
trong bãi chôn lấp chất thải rắn. Giai đoạn 2
có thể kéo dài sau một vài năm, thậm chí cả thập niên. Nước rò rỉ tạo ra
trong giai đoạn này có giá trị BOD
5
cao (thường lớn hơn 10.000 mg/l),
pH 5-6, nước rỉ đậm đặc, có mùi, nồng độ amonia cao (=< 1000 mg/l). Đặc
tính hoá học này, giúp hoà tan các thành phần khác trong rác dẫn đến nồng
độ cao của Fe, Mn, Zn, Ca, Mg trong nước rác. Khí sinh ra chủ yếu là
Công ty Cổ phần Đầu tư Phát triển Công nghệ APTCO
3
Xử lý nước rỉ rác tại bãi chôn lấp chất thải rắn Kiêu Kỵ - Gia lâm
CO
2
, mùi và hydrogen với hàm lượng ít hơn.
- Giai đoạn 3 – Giai đoạn lên men metan: Sự phát triển của vi khuẩn
methane dần dần trở nên chiếm ưu thế và bắt đầu phân huỷ những hợp
chất đơn giản, tạo ra các hỗn hợp khí CO
2
và CH
4
(cộng với một số
thành phần dạng vết khác) tạo nguồn khí của bãi chôn lấp chất thải rắn.
Chúng sử dụng những hợp chất hữu cơ hoà tan (chủ yếu là những axit
béo) là thành phần chính trong nước rò rỉ ở giai đoạn 2. Những vi khuẩn
này là loại kỵ khí và chuyển đổi các hợp chất hữu cơ hoà tan thành
methane (CH
4
) và CO
2
, mà sau đó thoát ra ngoài. Lúc này tốc độ sinh
khí giảm đáng kể do phần lớn các chất dinh dưỡng đã dùng hết qua các
pha trước và chất nền còn lại thì khả năng phân huỷ sinh học khá chậm.
Suốt pha này, nước rác chứa các chất hữu cơ trơ như axit humic và
fulvic rất khó phân huỷ sinh học. Nước rò rỉ tạo ra trong suốt giai đoạn 3
thường ổn định. Trong giai đoạn này hoạt động về mặt sinh học được xem
là hiệu quả nhất. Nước rò rỉ tạo ra trong giai đoạn 3 có hàm lượng BOD
5
tương đối thấp, tỷ số BOD
5
/COD thấp. Tuy nhiên ammonia vẫn tiếp tục
sinh ra từ quá trình lên men axit theo bậc 1 và có nồng độ rất cao
trong
nước rò rỉ. Các chất vô cơ như: Fe, Na, K, SO
4
2-
và Cl
-
tiếp tục tan và rỉ ra
từ bãi
chôn lấp trong nhiều năm.
3.2. Thành phần và tính chất của nước rác
Thành phần nước rác thay đổi rất nhiều, từ bãi chôn lấp chất thải rắn
này đến bãi chôn lấp chất thải rắn khác. Thành phần của nước rác chịu ảnh
hưởng các yếu tố sau:
Thành phần rác
Tuổi bãi chôn lấp chất thải rắn
Chế độ vận hành của bãi chôn lấp chất thải rắn, chiều cao chất rác
Thời tiết
Điều kiện thuỷ văn khu vực
Hoạt động hoá học, sinh học, lượng ẩm, nhiệt độ, pH, mức độ ổn
Công ty Cổ phần Đầu tư Phát triển Công nghệ APTCO
4
Xử lý nước rỉ rác tại bãi chôn lấp chất thải rắn Kiêu Kỵ - Gia lâm
định
Sự biến thiên nồng độ của các chất ô nhiễm theo tuổi của bãi chôn lấp chất
thải rắn được trình bày trong bảng dưới đây.
Bảng 1 Sự biến thiên nồng độ chất ô nhiễm trong nước rác theo tuổi bãi chôn
lấp chất thải rắn
Thành phần Đơn vị
Giá
trị
1 năm 5 năm 16 năm
BOD
COD
pH
Độ kiềm
Độ cứng
P tổng
N-NH
3
N-NO
3
-
Cl
-
Ca
Fe
Mg
Mn
Cu
Zn
mg/l
mg/l
mg/l
CaCO
3
mg/l
CaCO
3
mg/l
mg/l
mg/l
mg/l
mg/l
mg/l
mg/l
mg/l
mg/l
mg/l
7.500 –
28.000
10.000 –
40.000
5,2 –
6,4
800 –
4.000
3.500 –
5.000
25 –
35
56 –
482
0,2 –
0,8
600 –
800
900 –
1.700
210 –
325
160 –
250
75 –
125
_
10 -
30
4.000
8.000
6,3
5.810
2.200
12
_
0,5
1.330
308
6,3
450
0,06
<
0,5
0,4
80
400
_
2.250
540
8
_
1,6
70
109
0,6
90
0,06
<
0,5
0,1
Nguồn : Chian và DeWalle 1976, 1977
Nhìn chung ở những bãi chôn lấp chất thải rắn mới (giai đoạn axit), nước
rác thường có pH thấp, nồng độ BOD
5
, TOC, COD và kim loại nặng cao. Ở
những bãi chôn lấp chất thải rắn lâu năm (giai đoạn methane của quá trình
phân huỷ), pH = 6,5 – 7,5. Nồng độ chất ô nhiễm cũng giao động theo mùa
trong năm (mùa mưa và mùa khô).
Thành phần nước rác từ chất thải rắn sinh hoạt có hàm lượng chất ô
nhiễm sinh học và vi sinh gây bệnh cao. Trong khi đó nước rò rỉ từ bãi
chôn lấp chứa chất thải công nghiệp thường có hàm lượng ô nhiễm vô cơ
và kim loại nặng cao. Nói cách khác , thành phần tính chất nước rò rỉ liên
quan chặt chẽ với thành phần đặc trưng của rác.
Công ty Cổ phần Đầu tư Phát triển Công nghệ APTCO
5
Xử lý nước rỉ rác tại bãi chôn lấp chất thải rắn Kiêu Kỵ - Gia lâm
Bảng 2 Thành phần và tính chất nước rác điển hình
Thành phần Đơn vị
Bãi
mới
Bãi lâu
năm
(Trên 10
n
ăm)
Khoảng Trung bình
BOD
5
COD
N-hữu cơ
N-NH
3
Nitrat
Tổng photpho
Độ kiềm
pH
Canxi
Clorua
Tổng sắt
mg/l
mg/l
mg/l
mg/l
mg/l
mg/l
mg/lCaCO
3
mg/l
mg/l
mg/l
2000 -
30000
3000 -
60000
10 -
800
10 -
800
5 -
40
5 -
100
1000 -
10000
4,5 -
7,5
50 -
1500
200 -
3000
50 -
1200
10000
18000
200
200
25
30
3000
6
250
500
60
100 –
200
100 –
500
80 –
120
20 –
40
5 –
10
5 –
10
200 –
1000
6,6 –
7,5
50 –
200
100 –
400
20 -
200
Nguồn : Tchobanoglous et.al 1993
Thành phần rác thải bao gồm cả hữu cơ và vô cơ vì vậy nồng độ các chất
trong nước rỉ rác cao, mức độ nguy hại lớn. Kết quả phân tích mẫu nước rỉ rác lấy
ngày 5/10/2009 tại bãi chôn lấp chất thải rắn Kiêu Kỵ như sau:
Bảng 3. Kết quả phân tích chất lượng nước hồ sinh học
TT Chỉ tiêu Kết quả TCVN 5945 – 2005
với nguồn loại B
1 Nhiệt độ,
o
C 21,8 40
2 pH 5 5,5 -90
3 DO, mg/l 3,0 -
4 BOD
5
, mg/l 930 50
5 COD, mg/l 1538 80
6 Căn lơ lửng, mg/l 70 100
7 N-hữu cơ 250 -
8 N-NH
3
297
9 Phốt pho 17,5
10 Hg, mg/l KPH 0,01
11 As, mg/l KPH 0,1
12 Pb, mg/l KPH 0,5
13 Cd, mg/l KPH 0,01
14 Ca2+ 240
15 Mg2+ 356
16 Fe tổng 180
17 Tổng Coliform, MPN/100 ml 120 x 10
2
50 x 10
2
Công ty Cổ phần Đầu tư Phát triển Công nghệ APTCO
6
Xử lý nước rỉ rác tại bãi chôn lấp chất thải rắn Kiêu Kỵ - Gia lâm
Ghi chú: KPH: Không phát hiện thấy
Phân tích từ các bảng số liệu cho thấy rằng sau một thời gian phân huỷ,
hàm lượng BOD, COD đã giảm nhiều so với thời gian trước đây, tuy vậy hàm
lượng các chất ô nhiễm vẫn còn khá cao (COD, BOD
5
gấp nhiều lần tiêu chuẩn
cho tiêu chuẩn cho phép). Hàm lượng SS cũng giảm vì nước rác đã lắng khá lâu.
Hiện nay pH dao động trong khoảng 4,5 – 5,5 do các axit humic, fulvic,
ammonia và một số hợp chất khác được tạo ra trong quá trình thủy phân các chất
hữu cơ. Tóm lại, nước rác lưu chứa trong các hồ và ứ đọng ở một số chỗ bị ô
nhiễm rất nặng, mùi hôi khó chịu. Nước có hàm lượng chất hữu cơ khó phân huỷ
sinh học, độ kiềm, ammonia và vi sinh gây bệnh cao.
3. HIỆN TRẠNG XỬ LÝ NƯỚC RỈ TẠI BÃI CHÔN LẤP CHẤT THẢI
RẮN KIÊU KỴ
Tại các bãi tập kết, rác sau đó được chôn lấp và sinh ra một lượng lớn nước
rác. Bãi chôn lấp chất thải rắn chưa có hệ thống xử lý nước rác, hàng ngày lượng
nước này thấm dần vào đất gây suy giảm chất lượng nước ngầm từ đó đe doạ đến
sức khoẻ người dân.
Bãi chôn lấp chất thải rắn Kiêu Kỵ hiện có hệ thống xử lý nước rác với giai
đoạn chính là:
- Nước rác từ các hố chôn rác được quy tụ, đưa vào hồ sinh học có diện
tích 6000 m
2
, với độ sâu 2 - 3 m => thể tích hồ sinh học là:
6000 m
2
* 2 - 3 m = 12.000 - 18.000 m
3
Với lưu lượng nước rác 150 m
3
/ngày, hồ sinh học có thể chứa nước rác tối
đa trong thời gian:
18.000 m
3
: 150 m
3
/ngày = 120 ngày.
Thời gian lưu nước rỉ rác tối thiểu trong hồ sinh học là:
12.000 m
3
: 150 m
3
/ngày = 80 ngày
Như vậy, trung bình nước rác lưu lại trong hồ sinh học trong vòng 100
ngày. Với khoảng thời gian này, một phần chất hữu cơ trong nước rác đã được
phân hủy. Tuy nhiên, do hàm lượng các chất trong nước rác quá cao nên lượng
oxi cần thiết để phân huỷ các chất không được cung cấp đủ. Vì vậy, để tăng
Công ty Cổ phần Đầu tư Phát triển Công nghệ APTCO
7
Xử lý nước rỉ rác tại bãi chôn lấp chất thải rắn Kiêu Kỵ - Gia lâm
cường khả năng phân huỷ các chất ô nhiễm, tại bãi chôn lấp chất thải rắn Kiêu kỵ
người ta đã tăng cường một số giải pháp bổ sung:
+ Gia tăng chế phẩm EM nhằm khử mùi hôi, tiêu diệt các vi sinh vật có hại
và thúc đẩy quá trình phân hủy các chất hữu cơ trong nước rác.
+ Lắp đặt các thiết bị sục khí kiểu guồng quay nửa nổi nửa chìm nhằm tăng
lượng oxi hòa tan để các vi sinh vật hiếu khí hoạt động hỗ trợ tiếp tục cho quá
trình phân hủy.
Tuy nhiên, theo kết quả đo, hàm lượng COD trong hồ sinh học vẫn có giá
trị trong khoảng 1538 mg/l, vượt nhiều lần so với TCVN 5945 - 2005. Lượng
nước này sau đó được đổ ra sông Cầu Bây. Rõ ràng, nước rác đã trở thành một
nguồn gây ô nhiễm nước sông, ảnh hưởng đến cuộc sống người dân xung quanh
khu vực.
Qua đó có thể thấy các ảnh hưởng do bãi tập kết rác đem lại đã được các
nhà quản lý quan tâm. Nhiều phương án khắc phục được áp dụng nhằm cải thiện
môi trường xung quanh khu vực xử lý rác. Tuy nhiên, kết quả đạt được chưa khả
quan. Vì vậy, vấn đề đặt ra đó là cần thiết nghiên cứu, xây dựng một hệ thống xử
lý nước rác mang lại hiệu quả cao với chi phí lắp đặt và vận hành thấp, có tính
hiệu quả cao cả về kinh tế và xã hội.
4. PHƯƠNG ÁN XỬ LÝ NƯỚC RỈ RÁC BẰNG CÔNG NGHỆ SINH
HỌC NÉN ÉP CỦA CÔNG TY CỔ PHẦN ĐẦU TƯ PHÁT TRIỂN CÔNG
NGHỆ VÀ TƯ VẤN XÂY DỰNG APTCO VIỆT NAM
4.1. Nguyên lý cơ bản
Sơ đồ nguyên lý cơ bản của hệ thống xử lý nước rỉ bãi chôn lấp chất thải
rắn bằng công nghệ sinh học nén ép như trình bày trong hình 1.
Công ty Cổ phần Đầu tư Phát triển Công nghệ APTCO
8
Xử lý nước rỉ rác tại bãi chôn lấp chất thải rắn Kiêu Kỵ - Gia lâm
Hình 1. Sơ đồ nguyên lý cơ bản của công nghệ sinh học nén ép
Quá trình hoạt động của hệ thống được giải thích như sau. Nước rỉ bãi
Công ty Cổ phần Đầu tư Phát triển Công nghệ APTCO
9
Thiết bị xử lý yếm
khí (UASB)
Thiết bị keo tụ
Hồ sinh học
Thiết bị lọc
sinh học
Bể lắng 2
Bể Aerotank
Xử lý thiếu khí
(anoxic)
Bể nén bùn
Nguồn
tiếp
nhận
Bùn
tuần
hoàn
Nước
tách
bùn
Chôn lấp
Bùn dư
Nước rác
Bùn
Máy thổi
khí
Máy thổi
khí
Hóa chất
Hóa chất
Xử lý nước rỉ rác tại bãi chôn lấp chất thải rắn Kiêu Kỵ - Gia lâm
chôn lấp chất thải rắn được gom tại hồ sinh học đã xây dựng trong các giai đoạn
trước. Hồ này có dung tích khoảng 6000m
3
.
Như kết quả phân tích cho thấy tỉ lệ BOD
5
/COD = 1538/930 = 0,6 cho
thấy rằng nước rác có thể xử lý bằng các biện pháp sinh học. Tuy nhiên, do trong
nước rác có chứa nhiều chất độc (như KLN, các hợp chất khó phân hủy, NH
4
+
ở
nồng độ cao) sẽ ức chế hoạt động phân hủy các hợp chất hữu cơ của vi sinh
vật.Chính vì vậy, đòi hỏi phải làm giảm nồng độ NH
4
+
có trong nước rác trước
khi xử lý bằng biện pháp sinh học.
Nước thải tại hồ được bơm lên được đưa vào bể phản ứng. Tại đây chúng
tôi sử dụng phenton để oxy hóa các hợp chất hữu cơ khó phân hủy sinh học (axit
humic, fuvic ) thành các hợp chất đơn giản dễ phân hủy sinh học.
Gốc
•
OH của phenton tham gia vào phản ứng ôxi hóa các hợp chất hữu cơ có
trong nước cần xử lý: chuyển chất hữu cơ từ dạng cao phân thành các chất hữu cơ
có khối lượng phân tử thấp
CHC
(cao phân tử)
+
•
HO → CHC
(thấp phân tử)
+CO
2
+H
2
O+ OH
-
• Trung hòa và keo tụ
Sau khi xảy ra quá trình oxi hóa cần nâng pH dung dịch lên >7 để thực hiện
kết tủa Fe
3+
mới hình thành:
Fe
3+
+ 3OH
-
→Fe(OH)
3
Kết tủa Fe(OH)
3
mới hình thành sẽ thực hiện các cơ chế keo tụ, đông tụ, hấp
phụ một phần các chất hữu cơ chủ yếu là các chất hữu cơ cao phân tử.
bể điều chỉnh pH và keo tụ nhằm làm giảm nồng độ chất rắn lơ lửng và kết tủa
các ion kim loại nặng có trong nước rác. Tại đây chúng tôi sử dụng sữa vôi để
điều chỉnh pH đạt tới 10,5-11,5 nhằm kết tủa hoàn toàn các ion kim loại có trong
nước thải. Chúng ta biết rằng ammonia (NH
4
+
) có thể bị tách ra khỏi nước thải
bằng quá trình tách khí dựa trên cơ sở cân bằng hoá học:
NH
4
+
+ OH
-
→ NH
3
+ H
2
O
Phần lớn ammonia chuyển sang dạng khí ở pH cao, thường trong
khoảng 10,5 -11,5. Do đó, pH là một yếu tố ảnh hưởng rất lớn đến hiệu quả quá
Công ty Cổ phần Đầu tư Phát triển Công nghệ APTCO
10
Xử lý nước rỉ rác tại bãi chôn lấp chất thải rắn Kiêu Kỵ - Gia lâm
trình. Bên cạnh đó quá trình còn rất nhạy cảm với sự thay đổi của nhiệt độ, nhiệt
độ cảng giảm thì độ hoà tan ammonia càng tăng. Vì vậy, nhiệt độ giảm thì lượng
không khí cần cung cấp tăng đáng kể nhu cầu năng lượng sử dụng. Tuy nhiên, do
nước ta là nước nhiệt đới, nhiệt độ trung bình năm 20-25
o
C nên mức độ ảnh
hưởng của nhiệt độ đến quá trình là không lớn.
Các bông keo sau khi hình thành sẽ lắng xuống khiến làm giảm COD,
mầu, mùi, làm tăng tỉ lệ BOD
5
/COD trong nước thải. Sau quá trình lắng các chất
hữu cơ còn lại (nếu có) trong nước thải chủ yếu là các hợp chất hữu cơ có khối
lượng phân tử thấp sẽ được xử lý bổ sung bằng phương pháp sinh học hoặc bằng
các phương pháp khác. Các cặn lắng sẽ được xả định kỳ và đưa trở lại bãi chôn
lấp chất thải rắn để chôn lấp.
Tiếp đó nước rác sẽ được bơm lên hệ thống xử lý sinh học yếm khí.
Tháp này sẽ xử lý khoảng 80% hàm lượng ô nhiễm. Tháp xử lý sinh học yếm khí
này cao 6m, có đường kính 3,2m, làm bằng thép cường độ cao dày 3mm. Sơn
phủ chống ăn mòn cả trong và ngoài bằng composite cao cấp. Nước rác được bố
phân phối một cách đồng đều trên toàn bộ tiết diện tháp. Nước rác được đưa từ
dưới lên nhằm tận dụng áp lực của nước để khuấy trộn nhằm tăng khả năng tiếp
xúc của nước rác với vi sinh vật dẫn đến làm tăng tốc độ phân hủy chất hữu cơ.
Sản phẩm của quá trình phân hủy là khí gas CH
4
, có thể được dùng như một sản
phẩm phụ của quá trình xử lý.
Sau khi ra khỏi tháp nén ép sinh học thì nước rác được đưa vào bộ phận
xử lý thiếu khí (anoxic) để khử nitơ.
Phương trình năng lượng sử dụng methanol, ammonia-N làm chất nhận
electron được viết như sau:
NO
3
-
+ 2,5CH
3
OH + 0,24H
2
CO
3
→ 0,5C
5
H
7
O
2
N + 0,5N
2
+ 4,5 H
2
O + 0,5HCO
3
-
Sử dụng methanol làm nguồn carbon chuyển nitrate thành khí nitơ: Nhu cầu oxy
bị giảm 2,86 g / g nitrate bị khử .Độ kiềm (CaCO3) sinh ra là 3,57 g / g
nitrate bị khử nếu nitrate là nguồn nitơ cho tổng hợp tế bào. Còn nếu
ammonia-N có sẳn, độ kiềm sinh ra thấp hơn từ 2,9 - 3 g/l CaCO3/ g nitrate bị
khử.
Công ty Cổ phần Đầu tư Phát triển Công nghệ APTCO
11
Xử lý nước rỉ rác tại bãi chôn lấp chất thải rắn Kiêu Kỵ - Gia lâm
Tiếp đó nước rác được dẫn xuống bể xử lý hiếu khí (aerotank). Tại đây,
nước rác được bổ sung oxy thông qua các đĩa phân phối khí đặt ở dưới đáy bể để
tạo ra khí oxy dạng bọt nhằm làm tăng khả năng hòa tan của oxy trong nước. Các
vi sinh vật sử dụng oxy hòa tan trong nước để oxy hóa các chất hữu cơ còn lại
trong dòng thải.
Bể phản ứng sinh học hiếu khí – Aeroten là công trình bê tông cốt thép
hình khối chữ nhật hoặc hình tròn, cũng có trường hợp người ta chế tạo các
Aerotan bằng sắt thép hình khối trụ. Thông dụng nhất hiện nay là các Aeroten
hình bể khối chữ nhật. Nước thải chảy qua suốt chiều dài của bể và được sục khí,
khuấy nhằm tăng cường lượng khí oxi hòa tan và tăng cường quá trình oxi hóa
chất bẩn hữu cơ có trong nước.
Nước thải còn chứa phần lớn các chất hữu cơ ở dạng hòa tan cùng các chất
lơ lửng đi vào Aeroten. Các chất lơ lửng này là một số chất rắn và có thể là các
chất hữu cơ chưa phải là dạng hòa tan. Các chất lơ lửng làm nơi vi khuẩn bám
vào để cư trú, sinh sản và phát triển, dần thành các hạt cặn bông. Các hạt này dần
dần to và lơ lửng trong nước. Chính vì vậy xử lý nước thải ở Aeroten được gọi là
quá trình xử lý với sinh vật lơ lửng của quần thể vi sinh vật. Các bông cặn này
cũng chính là bùn hoạt tính. Bùn hoạt tính là loại bùn xốp chứa nhiều vi sinh vật
có khả năng oxi hóa và khoáng hóa các chất hữu cơ chứa trong nước thải. Để giữ
cho bùn hoạt tính ở trạng thái lơ lửng và để đảm bảo oxi dung cho quá trình oxi
hóa các chất hữu cơ thì phải luôn luôn đảm bảo việc thoáng gió. Số lượng bùn
tuần hoàn và số lượng không khí cần cấp lấy phụ thuộc vào độ ẩm vào mức độ
yêu cầu xử lý nước thải.Thời gian nước lưu trong bể aeroten không lâu quá 12
giờ (thường là 4 -8 giờ).
Quá trình oxi hóa các chất bẩn hữu cơ xảy ra trong aeroten qua ba giai đoạn:
- Giai đoạn thứ nhất: tốc độ oxi hóa bằng tốc độ tiêu thụ oxi. Ở giai đoạn
này bùn hoạt tính hình thành và phát triển. Hàm lượng oxi cần cho vi sinh
vật sinh trưởng, đặc biệt ở thời gian đầu tiên thức ăn dinh dưỡng trong
nước thải rất phong phú, lượng sinh khối trong thời gian này rất. Sau khi
Công ty Cổ phần Đầu tư Phát triển Công nghệ APTCO
12
Xử lý nước rỉ rác tại bãi chôn lấp chất thải rắn Kiêu Kỵ - Gia lâm
vi sinh vật thích nghi với môi trường, chúng sinh trưởng rất mạnh theo
cấp số nhân. Vì vậy, lượng tiêu thụ oxi tăng cao dần.
- Gian đoạn hai: vi sinh vật phát triển ổn định và tốc độ tiêu thụ oxi cũng
ở mức gần như ít thay đổi. Chính ở giai đoạn này các chất bẩn hữu cơ bị
phân hủy nhiều nhất.
Hoạt lực enzym của bùn hoạt tính trong giai đoạn này cũng đạt tới mức cực
đại và kéo dài trong một tời gian tiếp theo. Điểm cực đại của enzym oxi hóa
của bùn hoạt tính thường đạt ở thời điểm sau khi lượng bùn hoạt tính (sinh
khối vi sinh vật) tới mức ổn định.
Qua các thông số hoạt động của aeroten cho thấy ở gian đoạn thứ nhất tốc độ
tiêu thụ oxi (hay tốc độ oxi hóa) rất cao, có khi gấp 3 lần ở giai đoạn thứ hai.
- Giai đoạn thứ ba: sau một thời gian khá dài tốc độ oxi hóa cầm chừng
(hầu như ít thay đổi) và có chiều hướng giảm, lại thấy tốc độ tiêu thụ oxi
tăng lên. Đây là giai đoạn nitrat hóa các muối amon.
Sau cùng, nhu cầu oxi lại giảm và cần phải kết thúc quá trình làm việc của
aeroten (làm việc theo mẻ). Ở đây cần lưu ý rằng, sau khi oxi hóa được 80-95%
BOD trong nước thải, nếu không khuấy đảo hoặc thổi khí, bùn hoạt tính sẽ lắng
xuống đáy, cần phải lấy bùn cặn ra khỏi nước. Nếu không kịp thời tách bùn, nước
sẽ bị ô nhiễm thứ cấp, nghĩa là sinh khối vi sinh vật trong bùn (chiếm tới 70%
khối lượng cặn bùn) sẽ bị tự phân. Tế bào vi khuẩn có hàm lượng protein rất cao
(60-80% so với chất khô), ngoài ra còn có các hợp chất chứa chất béo,
hidratcacbon, các chất khoáng…khi bị tự phân sẽ làm ô nhiễm nguồn nước.
Tại đây cũng xảy ra quá trình nitrat hóa (Nitrification) . Quá trình nitrat
hoá là quá trình oxy hóa hợp chất chứa nitơ, đầu tiên là ammonia được chuyển
hoá thành nitrit sau đó nitrit được oxy hóa thành nitrat. Quá trình nitrat hoá
được diễn ra theo hai bước liên quan đến hai chủng loại vi sinh vật tự
dưỡng Nitrosomonas và Nitrobacter.
Bước 1: Ammonia được chuyển hoá thành nitrit được thực hiện bởi loài
Nitrosomonas:
Công ty Cổ phần Đầu tư Phát triển Công nghệ APTCO
13
Xử lý nước rỉ rác tại bãi chôn lấp chất thải rắn Kiêu Kỵ - Gia lâm
NH
4
+
+ 1,5 O
2
→ NO
2
-
+ 2 H
+
+ H
2
O (1)
Bước 2 : Nitrit được chuyển hoá thành nitrat được thực hiện bởi loài Nitrobacter:
NO
2
-
+ 0,5 O
2
→ NO
3
-
(2)
Phương trình phản ứng (1) và (2) tạo năng lượng. Theo Painter (1970), năng
lượng tạo ra từ quá trình oxy hoá ammonia khoảng 66-84 kcal/mol ammonia và
từ oxy hoá nitrit khoảng 17,5 kcal/mol nitrit. Nitrosomonas và Nitrobacter sử
dụng năng lượng này cho sự sinh trưởng của tế bào và duy trì sự sống. Tổng hợp
hai phản ứng được viết lại như sau:
NH
4
+
+ 2 O
2
→ NO
3
-
+ 2 H
+
+ H
2
O (3)
Từ phương trình (3), lượng oxy tiêu thụ là 4,57 g/g NH
4
+
-N bị oxyhoá, trong đó
3,43 g/g sử dụng cho tạo nitrit và 1,14 g/g sử dụng cho tạo nitrat, 2 đương lượng
ion H
+
tạo ra khi oxy hoá 1 mol ammonium, ion H
+
trở lại phản ứng với 2
đương lượng ion bicacbonate trong nước thải. Kết quả là 7,14 g độ kiềm
CaCO
3
bị tiêu thụ/g NH
4
+
bị oxyhoá. Phương trình (3) sẽ thay đổi chút ít khi quá
trình tổng hợp sinh khối được xem xét đến, nhu cầu oxy sẽ ít hơn 4,57 g do
oxy còn nhận được từ sự cố định CO
2
, một số ammonia và bicacbonate đi
vào trong tế bào. Cùng với năng lượng đạt được, ion ammonium được tiêu
thụ vào trong tế bào. Phản ứng tạo sinh khối đươc viết như sau:
4 CO
2
+ HCO
3
-
+ NH
4
+ H
2
O → C
5
H
7
O
2
N + 5 O
2
- Theo U.S.EPA Nitrogen Control Manual (1975): toàn bộ phản ứng oxy hoá và
tổng hợp sinh khối được viết như sau:
NH
4
+
+ 1,83 O
2
+ 1,98 HCO
3
-
→ 0,021 C
5
H
7
O
2
N + 0,98 NO
3
-
+ 1,041 H
2
O +
1,88 H
2
CO
3
Nhu cầu oxy là 4,2 g/g NH
4
+
-N bị oxy hoá.
- Theo Gujer và Jenkins (1974) : toàn bộ phản ứng oxy hoá và tổng hợp sinh
khối được viết như sau:
Công ty Cổ phần Đầu tư Phát triển Công nghệ APTCO
14
Xử lý nước rỉ rác tại bãi chôn lấp chất thải rắn Kiêu Kỵ - Gia lâm
1,02 NH
4
+
+ 1,89 O
2
+ 2,02 HCO
3
-
→ 0,021 C
5
H
7
O
2
N + NO
3
-
+ 1,06 H
2
O +
1,92 H
2
CO
3
Nhu cầu oxy giảm xuống còn 4,3 gO
2
/gNH
4
+
bị oxy hoá, độ kiềm tiêu thụ tăng
lên 7,2 g/g NH
4
+
bị oxy hoá.
Nước thải với bùn hoạt tính tuần hoàn sau khi qua bể aeroten cho qua bể
lắng đợt 2 Bể lắng đợt hai có nhiệm vụ chắn giữ các bông bùn hoạt tính đã qua
xử lý ở bể Aerotank và các thành phần tính chất không hoà tan. Hỗn hợp nước –
bùn hoạt tính từ bể Aerotank được đưa liên tục sang bể lắng đứng để loại bỏ bùn
hoạt tính trước khi dẫn đến công trình xử lý tiếp theo. Nước thải đươc dẫn vào
ống trung tâm. Ống trung tâm ở thiết bị lắng đứng được thiết kế sao cho nước khi
ra khỏi ống trung tâm có vận tốc nước đi lên trong thiết bị chậm nhất (trạng thái
tĩnh), khi đó các bông cặn hình thành có tỉ trọng đủ lớn để thắng được vận tốc của
dòng nước thải đi lên sẽ lắng xuống đáy của thiết bị lắng. Nước thải ra khỏi thiết
bị có nồng độ COD giảm 70 – 80%. Bùn lắng một phần được tuần hoàn trở lại
Aeroten để đảm bảo nồng độ bùn hoạt tính trong bể, phần khác đưa tới bể nén
bùn.
Tiếp đó, nước rác được đưa tới bể lọc sinh học nhỏ giọt (biophin). Lọc
nhỏ giọt là loại bể lọc sinh học với vật liệu tiếp xúc không ngập nước. Bể biophin
xây dựng dưới dạng hình tròn có tường đặc và đáy kép. Đáy trên là tấm đan đỡ
lớp vật liệu lọc, đáy dưới liền khối không thấm nước. Chiều cao giữa hai lớp đáy
lấy khoảng 0,4-0,6 m, độ dốc hướng về máng thu I >= 0,01. Dộ dốc theo chiều
dài của máng thu lấy theo kết cấu, nhưng không được nhỏ hơn 0,005. Tường bể
làm cao hơn lớp vật liệu lọc 0,5 m.
Đặc điểm riêng của bể biophin nhỏ giọt là kích thước của vật liệu lọc không lớn
hơn 25-30 mm và tải trọng tưới nước nhỏ 0,5-1,0 m
3
/(m
3
.VLL)
Công ty Cổ phần Đầu tư Phát triển Công nghệ APTCO
15
Xử lý nước rỉ rác tại bãi chôn lấp chất thải rắn Kiêu Kỵ - Gia lâm
Các vật liệu lọc có độ rỗng và diện tích mặt tiếp xúc trong một đơn vị thể
tích là lớn nhất trong điều kiện có thể. Nước đến lớp vật liệu lọc chia thành các
dòng hoặc hạt nhỏ chảy thành lớp mỏng qua khe hở của vật liệu, đồng thời tiếp
xúc với màng sinh học ở trên bề mặt vật liệu và được làm do vi sinh vật của
màng phân hủy hiếu khí các chất hữu cơ có trong nước. Các chất hữu cơ phân
hủy hiếu khí sinh ra CO
2
và nước. Khi lớp màng sinh học dày lên thì các vi khuẩn
ở lớp trong sẽ thiếu oxy nên sẽ chết đi làm tróc màng ra khỏi vật liệu mang, bị
nước cuốn theo. Trên mặt giá mang là vật liệu lọc lại hình thành lớp màng mới.
Hiện tượng này được lặp đi lặp lại nhiều lần. Kết quả là BOD của nước thải bị vi
sinh vật sử dụng làm chất dinh dưỡng và nước thải được làm sạch.
Nước thải trước khi đưa vào xử lý ở lọc phun (nhỏ giọt) cần phải qua xử lý
sơ bộ để tránh tắc nghẽn các khe trong vật liệu. Nước sau khi xử lý ở lọc sinh học
thường nhiều chất lơ lửng do các mảnh vỡ của màng sinh học cuốn theo, vì vậy
cần phải được lắng trước khi thải ra. Bể biophin được thiết kế với ngăn lắng ở
đáy nhằm hạn chế lượng chất rắn lơ lửng trước khi thải ra.
Cuối cùng trước khí thải ra ngoài, nước được đưa qua một ruộng chảy
tràn. Ruộng chảy tràn là một kênh xây bằng gạch, có độ rộng 2,5m, sâu 0,5, dài
100m. Trong ruộng xếp các lớp vật liệu lọc thành 3 lớp, tạo ra các khe kẽ làm
chậm dòng chảy để lắng bùn hiếu khí. Trên mặt ruộng có trồng cây sậy họ Caulis
Bambues in Taniis. Đây là một loại cây có khả năng hấp phụ mạnh các kim loại
nặng như Ni, Cr, Mn, Hg, Zn,… Ngoài ra cây sậy còn phân huỷ nhanh Nitơ và
Phôt pho, cũng như Lưu huỳnh tồn dư của các quá trình trước đó. Ruộng chảy
tràn có thể phân huỷ được gần 10% chất ô nhiễm, đặc biệt các thành phần khó
phân huỷ như kim loại nặng.
5. Cơ sở khoa học của công nghệ nén ép sinh học
Nước rỉ rác có chứa nhiều các chất vô cơ và hữu cơ. Thành phần hoá học
của nước rỉ rác rất phức tạp và không đồng nhất, do việc phân loại rác ở nước ta
chưa được thực hiện tốt. Có nhiều công nghệ xử nước rỉ rác khác nhau. Công
nghệ xử lý nước rác tiên tiến hiện nay trên thế giới là sử dụng màng lọc Nano.
Công ty Cổ phần Đầu tư Phát triển Công nghệ APTCO
16
Xử lý nước rỉ rác tại bãi chôn lấp chất thải rắn Kiêu Kỵ - Gia lâm
Công nghệ này đã từng được ứng dụng tại bãi chôn lấp chất thải rắn Gò Cát
nhưng chỉ sau vài ngày vận hành, thiết bị đã bị hỏng và không thể hoạt động như
dự kiến. Nguyên nhân chủ yếu đó là các chuyên gia nước ngoài chưa tiến hành
khảo sát kỹ thành phần rác và ở Việt Nam, rác được phân loại chưa tốt như các
quốc gia khác.
Hệ thống xử lý nước rỉ tại bãi chôn lấp chất thải rắn Kiêu Kỵ là hồ sinh học
có bổ sung chế phẩm EM và các thiết bị sục khí. Tuy nhiên hiệu quả đạt được
chưa cao, do nồng độ các chất ô nhiễm cao nên nhu cầu oxi hòa tan lớn. Hệ thống
xử lý này chưa cung cấp đủ lượng oxi cần thiết để có thể phân huỷ được hết các
chất vô cơ và hữu cơ trong nước rác.
Một hệ thống xử lý nước rác khác đã được lắp đặt tại khu liên hiệp xử lý
rác Nam Sơn với chi phí xây dựng lên đến trên 20 tỉ VNĐ và giá thành xử lý là
35.000đ/m
3
nước rác. Rõ ràng, kể cả khi hiệu quả xử lý của hệ thống tốt, nhưng
với chi phí lắp đặt và chi phí vận hành cao như trên thì khả năng nhân rộng của
hệ thống cũng rất khó khăn.
Vì vậy, công nghệ sinh học nén ép đã được nghiên cứu áp dụng nhằm tới
các mục tiêu :
- Xử lý nước rác đạt hiệu quả cao
- Chi phí đầu tư lắp đặt nhỏ
- Chi phí vận hành thấp,
- Hoạt động bền vững ổn định,
- Có khả năng nhân rộng,
Công nghệ sinh học nén ép được áp dụng dựa trên nguyên tắc xử lý yếm
khí nén ép bằng trọng lực, hiếu khí cưỡng bức và ruộng chảy tràn. Dưới đây sẽ
phân tích cơ sở khoa hoc của các hạng mục trên.
5.1. Xử lý yếm khí nén ép bằng trọng lực
Nguyên tắc yếm khí nén ép bằng trọng lực dựa trên cơ sở kích hoạt sự phát
triển cực nhanh của các vi khuẩn yếm khí đặc biệt trong môi trường lớp bùn bị
nén ép cường độ cao. Trong lớp bùn đó được cấy một số chủng vi sinh đặc biệt
giúp thúc đẩy nhanh quá trình phân huỷ các chất ô nhiễm. Nước thải sẽ được đưa
Công ty Cổ phần Đầu tư Phát triển Công nghệ APTCO
17
Xử lý nước rỉ rác tại bãi chôn lấp chất thải rắn Kiêu Kỵ - Gia lâm
vào đáy giếng, rồi chảy ngược dòng lên miệng giếng tràn ra ngoài. Vì nước đi
ngược nên theo trọng lực các phần tử lơ lửng tan trong dòng nước có xu hướng
rơi tự do xuống. Người ta phải thiết kế modul nén ép sao cho lực đẩy nước đi lên
cân bằng dương với trọng lực rơi xuống để nén ép thành lớp bùn đặc quánh. Suốt
quá trình nước thải ngược dòng dưới lên trên thì có 3 quá trình sinh hoá xảy ra
liên tục là thuỷ phân, axetat hóa và metan hóa.
Các vi sinh vật sử dụng trong xử lý nước thải.
Vi sinh vật sử dụng trong xử lý nước thải có các yêu cầu sau:
- Có khả năng oxy hoá mạnh các chất hữu cơ.
- Kích thước của vi sinh vật lớn, không phải dạng sợi, tảo nha bào, có khả
năng tạo bông hạt kết dính với nhau để tạo thành bùn sinh học.
- Trong một số trường hợp, nước thải có chứa các chất hữu cơ phức tạp
như các hợp chất Clo hữu cơ cần chọn các chủng loại vi sinh vật đặc biệt có
enzym phân huỷ được chúng.
Các vi khuẩn thường được sử dụng để tạo bùn hoạt tính trong xử lý nước
thải: Pseudomonas, Nitrobacter, Flavobacterium, Alcaligenes…Vi khuẩn hiếu khí
tuỳ tiện bao gồm các chi: Cellulomonas, Rodopseudomonas, Nitromonas.
Ngoài ra, tuy không mong muốn nhưng trong bùn hoạt tính sử dụng trong
quá trình xử lý nước thải thường gặp vi khuẩn dạng sợi (vi hiếu khí) như
Microthrix, Thiothrix, Besgiata…
Trong bùn hoạt tính còn có một thành phần quan trọng đó là nguyên sinh
động vật (Flagellata, Cillata…). Các thành phần nguyên sinh động vật có tác
dụng làm cho bùn xốp dễ kết lắng và một số loại sử dụng xác vi khuẩn chết là
nguồn thức ăn tạo cho bùn có tỉ lệ vi khuẩn sống cao, hoạt tính mạnh. Khi sử
dụng polime keo tụ thì các chất lơ lửng sẽ lắng xuống đáy. Quá trình metan hoá
là khâu quan trọng nhất trong tháp nén ép. Nó được viết như sau:
C
x
H
y
O
z
N + (x + y/4 + z/3 + 3/4) O
2
→
vatmenvisinh
xCO
2
+
2
3−y
H
2
O + NH
3
+ ∆H
C
x
H
y
O
z
N + NH
3
+ O
2
→
vatmenvisinh
C
5
H
7
NO
2
+ CO
2
+ ∆H
Công ty Cổ phần Đầu tư Phát triển Công nghệ APTCO
18
Xử lý nước rỉ rác tại bãi chôn lấp chất thải rắn Kiêu Kỵ - Gia lâm
Nếu tiếp tục tiến hành quá trình oxy hoá thì khi không đủ chất dinh dưỡng,
quá trình chuyển hoá các chất của tế bào bắt đầu xảy ra bằng việc oxy hoá chất
liệu tế bào (tự oxy hoá).
C
5
H
7
NO
2
+ 5O
2
→
vatmenvisinh
5CO
2
+ NH
3
+ 2H
2
O + ∆H
NH
3
+ O
2
→
vatmenvisinh
HNO
2
+ O
2
→
vatvisinh
HNO
3
Quá trình này sẽ tạo ra nhiều bùn, có thể làm giảm tới 85% tải lượng ô nhiễm.
5.2. Xử lý hiếu khí cưỡng bức
Khi nước đi ra khỏi tháp yếm khí nén ép sinh học thì đa số các thành phần
hữu cơ đã bi ba quá trình yếm khi phân huỷ. Khi đó chỉ còn các hạt bùn kích
thước nhỏ, mà bao ngoài nó là các vi khuẩn hiếu khí, chúng đang trong trạng thái
cực kỳ thiếu ô xy. Để thúc đẩy quá trình oxy hóa cần phải bổ sung cấp tập một
lượng lớn ô xy. Vì nếu đủ ô xy thì các vi khuẩn hiếu khí sẽ sinh trưởng bùng phát
sau một thời gian bị ức chế trong tháp nén ép yếm khí.
5.3. Ruộng chảy tràn
Ruộng chảy tràn là một phương pháp xử lý nước thải đang được ưa
chuộng nhất trên thế giới. Đại học Stockhom có hẳn một khoa gồm hơn 50 giáo
sư đang tập trung nghiên cứu vấn đề này. Tại Pháp có những cánh đồng thí
nghiệm ruộng chảy tràn rộng hơn 10 ha, cho phép xử lý gần như hầu hết các loại
nước thải. Bản chất của ruộng chảy tràn là làm ngập nước vào chân rễ các loại
cây kháng ô nhiễm. Các chất ô nhiễm chảy với lưu tốc bé trong ruộng sẽ dễ dàng
bị hấp thụ bởi rễ cây và được biến thành sinh khối. Trong các loại cây được trồng
trong ruộng chảy tràn thì cây sậy là chủng có tác dụng chống ô nhiễm cao nhất.
Trên thế giới đã có rất nhiều nghiên cứu về khả năng xử lý của các loại cây khác
nhau. Mỗi loài cây lại có một ưu điểm riêng, thích nghi với một hoàn cảnh nhất
định. Tuy nhiên, có thể nhìn thấy một cách tương đối rõ ràng rằng rễ cây sẽ làm
giảm tốc độ nước, qua đó tạo điều kiện thuận lợi cho việc lắng bùn thải được hình
thành trong quá trình xử lý hiếu khí. Rễ cây lấy chất dinh dưỡng từ các chất hữu
cơ có trong nước thải để tổng hợp nên các tế bào của chúng qua đó làm giảm chỉ
số BOD
5
. Chúng ta biết rằng thực vật được sử dụng trong xử lý chất ô nhiễm đòi
hỏi phải đáp ứng một số điều kiện cơ bản như dễ trồng, có khả năng vận chuyển
các chất ô nhiễm từ đất lên thân nhanh, chống chịu được với nồng độ các chất ô
nhiễm cao và cho sinh khối nhanh và mỗi loại cây có khả năng tích lũy một loại
Công ty Cổ phần Đầu tư Phát triển Công nghệ APTCO
19
Xử lý nước rỉ rác tại bãi chôn lấp chất thải rắn Kiêu Kỵ - Gia lâm
chất ô nhiễm đặc trưng (ví dụ như gần đây các nhà khoa học Việt Nam đã phát
hiện ra một loài cây dại có tên là thơm ổi thường mọc hoang dại ở Việt Nam cũng
có khả năng đặc biệt đó. Loài cây này có khả năng hấp thu kim loại nặng gấp 100
lần bình thường và sinh trưởng rất nhanh. Khả năng “ăn” kim loại nặng của thơm
ổi, tuy chưa bằng các loài dây leo, nhưng bù lại chúng lớn nhanh như thổi, rất dễ
trồng và chăm sóc. Loài cây này hút lượng chì khá lớn, trung bình cao gấp 500-
1.000 lần, thậm chí còn lên tới 5.000 lần so với cây đối chứng mà không bị ảnh
hưởng. Chúng được xem là loài siêu hấp thụ kim loại nặng là chì và cađimi ).
Ở đây chúng tôi sử dụng cỏ Vertive để xử lý nước thải. Đây là một loại cây
có khả năng tăng trưởng mạnh, chống chịu tốt trong điều kiện nồng độ chất hữu
cơ cao. Việc sử dụng cỏ Vertive để sử lý nước thải đã được nghiên cứu và ứng
dụng thành công trong thực tế ở điều kiện Việt Nam
Nước thải sau khi ra khỏi hệ thống xử lý hiếu khí sẽ được đưa vào ruộng
chảy tràn. Các loài thực vật làm giảm nhiều chất ô nhiễm, bao gồm các chất hữu
cơ, chất rắn lơ lửng, N
2
, P, kim loại, các vi sinh vật gây bệnh. Việc làm giảm các
chất này được thực hiện bởi các cơ chế xử lý đa dạng.
Hình 3: Mô hình bố trí các lớp của thảm thực vật trên ruộng chảy tràn
Cơ chế xử lý chất ô nhiễm của ruộng chảy tràn
Các chất hữu cơ lắng đọng được loại bỏ nhanh chóng dưới những điều kiện
nhất định do phân huỷ và thấm lọc. Sự sinh trưởng của các vi sinh vật bám dính
và lơ lửng loại bỏ các hợp chất hữu cơ hoà tan. Các hợp chất hữu cơ được phân
huỷ kị khí và hiếu khí. Oxy cần đến cho sự phân huỷ hiếu khí và nó được cung
cấp trực tiếp từ khí quyển bằng cách khuyếch tán hoặc ngấm sâu vào bầu rễ.
Công ty Cổ phần Đầu tư Phát triển Công nghệ APTCO
20
Cát vàng
Sỏi
Đất
**************
*
**************
*
•••••••••••••
•••••••••••••
••••••
Xử lý nước rỉ rác tại bãi chôn lấp chất thải rắn Kiêu Kỵ - Gia lâm
Hình 4. Một số hình ảnh về ruộng chảy tràn
Sự hấp thụ các vật chất hữu cơ bởi thực vật thuỷ sinh không đáng kể so với
sự phân huỷ sinh học. Sự phân huỷ hiếu khí các chất hữu cơ hoà tan được điều
chỉnh bởi nhóm các vi khuẩn dị dưỡng hiếu khí theo phản ứng sau:
(CH
2
O) + O
2
⇒ CO
2
+ H
2
O (1)
Nhóm vi khuẩn tự dưỡng phân huỷ chất hữu cơ chứa nitơ dưới điều kiện
hiếu khí gọi là vi khuẩn nitrat hoá, quy trình này được gọi là amoni hoá. Tất cả
các nhóm đều tiêu thụ chất hữu cơ nhưng tốc độ trao đổi chất của nhóm dị dưỡng
nhanh hơn, nghĩa là chúng gây ra chủ yếu sự giảm BOD của hệ thống. Khi không
đầy đủ oxy cho các nhóm này thì sẽ làm giảm nhiều sự biểu hiện của sự oxy hoá
sinh học hiếu khí, tuy nhiên, nếu oxy không được giới hạn, sự phân huỷ hiếu khí
sẽ được điều chỉnh bởi lượng các vật chất hữu cơ hoạt động có giá trị với các cơ
thể sống.
Sự phân huỷ kị khí là một quá trình có nhiều giai đoạn xẩy ra trong các
vùng đất ngập nước khi vắng mặt oxy hoà tan. Quá trình có thể thực hiện bởi các
nhóm vi khuẩn tự dưỡng bắt buộc hay không bắt buộc. Trong giai đoạn đầu tiên,
sản phẩm cuối cùng của sự lên men là các axit béo như axit acetic, butyric và
lactic, rượu, khí CO
2
và H
2
.
C
6
H
12
O
6
⇒ 3 CH
3
COOH + H
2
(2)
C
6
H
12
O
6
⇒ CH
3
CHOHCOOH (3)
C
6
H
12
O
6
⇒ 2 CO
2
+ 2CH3CH
2
OH (4)
Công ty Cổ phần Đầu tư Phát triển Công nghệ APTCO
21
Xử lý nước rỉ rác tại bãi chôn lấp chất thải rắn Kiêu Kỵ - Gia lâm
Axít sinh ra có thể làm giảm pH nhanh chóng, do đó dừng các hoạt động
của vi khuẩn tạo metan và dẫn đến việc tạo ra các hợp chất có mùi khó chịu từ
thảm thực vật. Sự phân huỷ kị khí các hợp chất hữu cơ chậm hơn nhiều sự phân
huỷ hiếu khí. Tuy nhiên, khi O
2
bị giới hạn mà lượng chất hữu cơ cao thì quá
trình yếm khí sẽ chiếm ưu thế.
Quá trình loại bỏ các chất rắn lơ lửng là các quá trình trầm tích và lọc, ít
nhất có một phần các chất rắn dạng keo được loại bỏ bởi sự phát triển của các vi
khuẩn. Trong tất cả các hệ thống thảm thực vật, hầu hết các chất thải rắn có
nguồn gốc từ nước thải được lọc qua và lắng đọng ở vài mét đầu của dòng vào.
Sự tích luỹ chất rắn lơ lửng là sự đe doạ chính cho hoạt động của một số hệ thống
đặc biệt là đối với các hệ thống có dòng chảy dưới lớp bề mặt, những dòng chảy
này có thể bị ngăn chặn bởi chất rắn lơ lửng. Tại nhiều hệ thống, phần lớn các
chất rắn lắng đọng được chuyển đi ở giai đoạn xử lý sơ cấp trước khi nước thải
được đưa vào hệ thống ngập nước hiện tại.
Tốc độ hấp thụ chất dinh dưỡng của thực vật giới hạn bởi khối lượng (tốc
độ tăng trưởng) và nồng độ các chất dinh dưỡng trong mô thực vật. Sự tích trữ
chất dinh dưỡng phụ thuộc vào nồng độ chất dinh dưỡng trong mô và cũng dựa
vào khả năng tích luỹ sinh khối cơ bản, đó là mức tăng trưởng tối đa. Bởi vậy nét
nổi bật của thực vật được sử dụng để đồng hoá chất dinh dưỡng và tích trữ có các
đặc trưng: sự tăng trưởng nhanh, tập trung chất dinh dưỡng cao, khả năng đạt
mức tăng trưởng cao (sinh khối trên một đơn vị diện tích).
Trong một số tài liệu có mô tả về nồng độ N
2
trong mô thực vật. Lượng
nitơ có thể được loại bỏ nếu thu hoạch sinh khối từ 1000–2500 kg N/ha/năm, có
thể lên tới gần 6000kg N/ha/năm. Tuy nhiên, chỉ vài số liệu đã được ghi lại với
thực vật từ đất ngập nước trong xử lý nước thải. Thêm vào đó, việc nhận ra rằng
lượng chất dinh dưỡng được loại bỏ do thu hoạch sinh khối không quan trọng so
với các dòng chảy nước thải trong đất ngập nước. Điều này đặc biệt đúng với các
vùng đất ngập nước với các loại thực vật nổi. Trong điều kiện loại bỏ Nitơ tối ưu
thì sinh khối có thể đạt 10 – 16% tổng lượng Nitơ loại bỏ. Nếu thảm thực vật
không được thu hoạch sinh khối thì một lượng lớn chất dinh dưỡng đi vào trong
mô thực vật sẽ quay trở lại nước do các quá trình phân huỷ. Sự tích trữ chất dinh
Công ty Cổ phần Đầu tư Phát triển Công nghệ APTCO
22
Xử lý nước rỉ rác tại bãi chôn lấp chất thải rắn Kiêu Kỵ - Gia lâm
dưỡng lâu dài trong hệ thống đất ngập nước là kết quả từ rác không phân huỷ
được tạo ra từ các yếu tố khác nhau của chu trình sinh hoá.
Nước sau khi chảy qua ruộng chảy tràn có thể xả trực tiếp ra môi trường.
Các thực vật ở ruộng được thu hoạch định kỳ 3 tháng một lần. Thực vật sau khi
thu hoạch được đem đốt nhằm tận thu năng lượng.
Ngoài ra, khi vận hành hệ thống còn có một ưu điểm lớn là rất ít trục trặc,
các tháp và ruộng cây đều được chế tạo và xây lắp bền vững. Do đó, phương án
sẽ hoạt động ổn định lâu dài.
Như vậy, có thể xem rằng phương án trình bày ở trên là an toàn về phương
diện công nghệ. Dưới đây chúng ta tiếp tục thảo luận về các khía cạnh kinh tế của
phương án.
Công ty Cổ phần Đầu tư Phát triển Công nghệ APTCO
23
Xử lý nước rỉ rác tại bãi chôn lấp chất thải rắn Kiêu Kỵ - Gia lâm
6. TÍNH TOÁN CÁC CÔNG TRÌNH ĐƠN VỊ
Các thông số để tính toán các công trình như trình bày sau đây
I. Tính toán bể UASB
UASB – bể xử lý sinh học dòng chảy ngược qua lớp bùn ( Upflow
anaerobic sludge blanket). Mô hình bể là hình trụ tròn gồm 2 phần: phần phân
huỷ và phần lắng. Nước thải được phân phối vào từ đáy bể và đi ngược lên qua
lớp bùn sinh học có mật độ vi khuẩn cao.
Khí sinh ra trong quá trình phân huỷ kỵ khí được thu vào phễu tách khí lắp
đặt phía trên. Để thu khí tập trung vào phễu không vào ngăn lắng , cần thiết có
tấm hướng dòng.
Sau thiết bị oxy hóa và keo tụ thì nồng độ các chất ô nhiễm trong dòng thải
là: COD: 1200mg/l
BOD5: 700mg/l
Các thông số đầu vào của bể UASB :
Q = 300m
3
/ngđ
BOD
5
= 700 mg/l
COD = 1200 mg/l
SS = 70mg/l
Thực nghiệm trên mô hình pilot rút ra được kết quả sau:
Bùn nuôi cấy ban đầu lấy từ bùn của bể phân huỷ kỵ khí từ quá trình xủa lý
nước thải sinh hoạt cho vào bể với hàm lượng 30kgSS/m
3
;
Tỉ lệ MLVS/MLSS của bùn trong bể UASB =0,75;
Tải trọng bề mặt phần lắng 12m
3
/m
2
.ngày;
ở tải trọng thể tích L
0
= 6 kg COD/m
3
.ngày, hiệu quả khử COD đạt 80%;
Lượng bùn phân huỷ kỵ khí cho vào ban đầu có TS=5%;
Y=0,04 gVSS/gCOD, k
đ
=0,025 ngày
-1
,t
c
=60 ngày.
Để giữ cho lớp bùn hoạt tính ở trạng thái lơ lửng, tốc độ nước dâng trong bể phải
giữ trong khoảng 0,6 - 0,9m/h . Chọn v=0,8 m/h.
Diện tích bề mặt cần thiết của bể:
Công ty Cổ phần Đầu tư Phát triển Công nghệ APTCO
24
Xử lý nước rỉ rác tại bãi chôn lấp chất thải rắn Kiêu Kỵ - Gia lâm
2
89,20
8,024
300
m
v
Q
A =
×
==
Chọn A = 15.6 m
2
Thể tích ngăn phản ứng bể UASB :
V
r
=
=×
××
=
××
g
kg
ngàymkgCOD
mgCODngàym
L
CQ
o
1000
1
./6
/12007,0/300
7,0
3
33
0
53,83 m
3
Chọn thể tích của bể V
r
= 54 m
3
Chiều cao phần xử lý yếm khí là
H =
m
m
m
A
V
r
46,3
6,15
54
2
3
==
Chọn chiều cao phần xử lý yếm khí là H = 3,5m
Chiều cao vùng lắng: h
p
= 1,5m; (Theo quy phạm h
p
=1,5-2m)
Chiều cao bảo vệ: h
bv
= 0,3m.
Chiều cao tổng cộng của bể UASB:
H
tc
= H + h
p
+ h
bv
= 3,5+2+0,3= 5,8 m
Chọn chiều cao của bể là 5,8 m
Thể tích thực của bể:
V
t
= A x H
tc
= 5,8 x 15,6 = 90,5 m
3
Thời gian lưu nước trong bể UASB:
t = V
t
/Q = (90,5 x 24)/300 = 7,24 (giờ)
Chia thiết bị thành 2 đơn nguyên hình trụ có đường kính d
d =
m
A
15,3
2
=
π
Lượng bùn nuôi cấy ban đầu cho vào bể (TS = 5%):
M
b
=
05,0
54/30
33
mmkgSS
TS
VC
rss
×
=
×
= 32400kg = 32.4 tấn
Trong đó:
C
ss
: hàm lượng bùn trong bể, kg/m
3
;
V
r
: thể tích ngăn phản ứng;
TS: hàm lượng chất rắn trong bùn nuôi cấy ban đầu, %.
Hàm lượng COD của nước thải sau xử lý kỵ khí:
COD
ra
= (1-E
COD
)COD
vào
=(1-0,7)1200 mg/l =360 mg/l
Công ty Cổ phần Đầu tư Phát triển Công nghệ APTCO
25